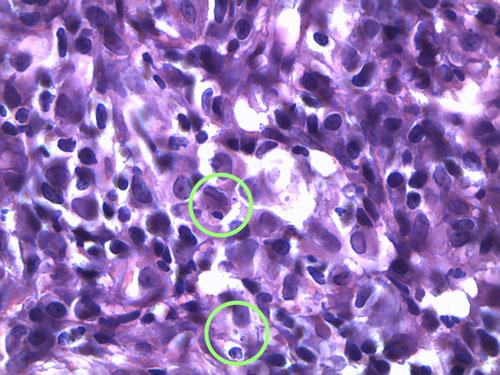
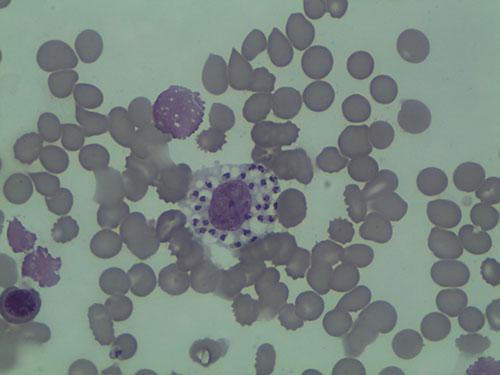

Auteur : Xavier Langon – Janvier 2015
Clinique vétérinaire de Camargue
34400 Lunel
Motif de consultation
Un chien croisé Épagneul-papillon est consulté pour une dermatose quadripodale évoluant depuis 3 semaines.
Commémoratifs et anamnèse
Un croisé Épagneul-papillon mâle, âgé de 7 ans, est présenté à la consultation pour boiterie sévère associée à une pododermatite quadripodale évoluant depuis 3 semaines (photo 1). L’animal vit en appartement sans congénère et est nourrit avec un aliment industriel. Il est à jour de sa vaccination et correctement traité contre les parasites internes et externes. Son passé pathologique est vierge. Son propriétaire ne rapporte aucune lésion le concernant.
Photo 1 : vue générale de l’animal.
Examen clinique
L’animal présente un bon état général mais présente une mobilité « algique ». Une déviation en valgus des carpes est relevée. Les lésions cutanées quadripodales concernent les espaces interdigités ainsi que les bords des coussinets principal et digité: érythème, alopécie, épaississement cutané, érosions et ulcérations. La dermatose est faiblement prurigineuse. Aucune autre lésion cutanée ne peut être mise en évidence (photos 2).
Photo 2a : Vue rapproché de la pose au sol de l’extrémité distale du membre antérieur gauche.
Photo 2b : Vue rapprochée de la pododermatite antérieure gauche.
Photo 2c : Vue rapproché de la pododermatite postérieure gauche.
Hypothèses diagnostiques
La symptomatologie et l’anamnèse nous amènent à envisager plusieurs hypothèses :
- Leishmaniose
- Érythème Nécrolytique migrant
- Une démodécie podale
Examens complémentaires
Les raclages cutanés ne mettent pas en évidence de Demodex.
Les calques cutanés révèlent la présence de très nombreux polynucléaires neutrophiles associés à des macrophages. Aucune leishmanie n’est notée sur le calque.
Plusieurs biopsies sont réalisées :
L’épiderme, hyperplasique, est le siège d’une hyperkératose parakératosique modérée à marquée. Un infiltrat diffus riche en macrophages, cellules dendritiques, mélanophages, plasmocytes et éosinophiles, est présent dans le derme. Les macrophages renferment de nombreux éléments ovalaires, bipolaires, rappelant des leishmanies (photos 3).
Photo 3a : Observation microscopique (x400) d’une biopsie cutané
Noter l’épiderme hyperplasique et l’hyperkératose parakératosique.
Photo 3b : Observation microscopique (x1000) d’une biopsie cutané
Noter la présence de nombreux macrophages et la présence
de Leishmanies dans leur cytoplasme.
Diagnostic
Pododermatite granulomateuse leishmanienne
Traitement et suivi
La gestion thérapeutique fait appel à une association d’allopurinol per os à 10 mg/kg BID pendant 1 mois (ZYLORIC®) et d’antimoniate de méglumine par voie SC pendant 4 semaines (GLUCANTIME®).
Le suivi repose sur un examen dermatologique intermédiaire à 15 jours, et un examen clinique complet à 1 mois incluant une NFS et un bilan biochimique. Les lésions cutanées régressent progressivement, l’animal présentant une locomotion nettement moins algique dès 15 jours. (photo 4)
Photo 4 : Vue rapprochée de la pododermatite leishmanienne à 15 jours.
Noter l’amélioration clinique
À 1 mois, la guérison dermatologique est nettement avancée (photo5), les constantes hémato-biochimiques sont dans la fourchette des valeurs usuelles. L’antimoniate de méglumine est arrêté et l’alluporinol est prescrit à 10 mg/kg SID pendant 12 mois. L’animal sera consulté mensuellement pendant les 6 premiers mois puis tous les 6 mois.
Photo 5 : Vue rapprochée de la pododermatite leishmanienne à 1 mois.
À 2 mois, la guérison dermatologique est atteinte avec une locomotion normale (photos 6)
Photos 6a à 6d : Vues rapprochées de la pododermatite leishmanienne à 2 mois.
À 6 mois de thérapie, le chien présente une guérison clinique et une sérologie positive. Le traitement est actuellement toujours en cours, sans rechute…
Discussion
La leishmaniose est une maladie infectieuse dont l’évolution et l’expression clinique sont le résultat d’une interaction complexe entre un protozoaire flagellé Leishmania infantum et le système immunitaire de l’animal infecté. (photo 7)
Photo 7 : Observation microscopique (x1000) d’un calque cutané
Noter la présence de nombreuses Leishmanies dans le cytoplasme du macrophage.
Épidémiologiquement, cette entité est enzootique autour du bassin méditerranéen avec une extension avérée vers le Nord et l’Ouest. La transmission du parasite repose essentiellement sur des populations importantes de phlébotomes infectés et infectants. La capacité de certains chiens de contrôler, pendant une durée variable, la multiplication et la dissémination du parasite grâce à une immunité cellulaire efficace, autorise l’établissement de diagnostics dans toute la France. Le traditionnel paradigme Th1/Th2 du système immunitaire représente la clé de voute de la compréhension de l’existence instable et intervertible de chien « résistants » et « sensibles ».
Sa symptomatologie est protéiforme, incluant des manifestations générales (lymphadénopathie, perte de poids, léthargie, anémie, PUPD, hyperthermie, splénomégalie, vomissement et diarrhée), des lésions oculaires (blépharite, kératoconjonctivite, uvéite), des lésions cutanéo-muqueuses ulcéreuses ou nodulaires, des boiteries (polyarthrites, polymyosites, névrites), épistaxis et vascularites. Sur un plan dermatologique, les lésions cutanées les plus fréquentes regroupent une dermatite exfoliante non prurigineuse (avec ou sans alopécie), une dermatite érosive ulcéreuse, nodulaire, papuleuse, pustuleuse et une onychodystrophie. Notre cas présente une lésion caractéristique d’ulcération de coussinets. Cette symptomatologie assez fruste, non spécifique et sans signe systémique doit évoquer une leishmaniose.
La démarche diagnostique, dans un contexte épidémiologique et clinique évocateur, repose d’abord sur une sérologie quantitative (IFI ou Elisa). Rappelons qu’une sérologie qualitative ne permet de conclure qu’à un contact entre des leishmanies et le système immunitaire de l’animal, mais ne permet pas de conclure à une leishmaniose clinique. Retenons tout de même qu’un chien « résistant » (Th1) possède en général un taux d’immunoglobulines (Ig) spécifiques bas, alors qu’un chien « sensible » (Th2) présente un taux élevé d’Ig spécifiques (non protectrices mais susceptibles de former des complexes immuns à l’origine des lésions tissulaires). Face à une sérologie quantitative négative ou douteuse, un adénogramme, myélogramme ou histologie doit être mis en œuvre pour une mise en évidence directe des leishmanies. Enfin, une négativité de tous ces tests conduit à une recherche en PCR à partir des mêmes prélèvements.
Le traitement de consensus en France associe l’antimoniate de méglumine (GLUCANTIME®) à 100 mg/kg SID par voie sous-cutanée pendant 1 mois et l’allopurinol (ZYLORIC®) à 10 mg/kg BID per os pendant une durée prolongée. Le suivi tient compte de la néphrotoxicité potentielle du premier et de l’apparition d’urolithiases par le second. Certains chien peuvent présenter une rechute plusieurs semaines à plusieurs mois plus tard, nécessitant une nouvelle cure thérapeutique si le fonctionnement rénal le permet. La miltéfosine (MILTEFORAN®) a démontré une efficacité à 2 mg/kg SID per os pendant 28 jours en association avec l’allopurinol, dans les stades I à III. Toutefois, cette molécule n’a pas d’A.M.M. en France, le niveau 3 de la Cascade serait requis pour autoriser son utilisation (alors que l’antimoniate de méglumine existe), et en tout état de cause il ne peut faire l’objet que d’un deuxième choix après l’association antimoniate de méglumine/allopurinol. (tableau des stades clinique des la leishmaniose)
Concernant la marbofloxacine, aucune donnée publiée n’est disponible pour recommander l’utilisation de cette molécule pour traiter la leishmaniose canine (hormis l’étude pilote proposée par le laboratoire titulaire de la molécule en 2008). Dans le contexte actuel de l’utilisation raisonnée des antibiotiques, il n’est donc pas recommandé de l’utiliser.
L’amphotéricine B (lui aussi sans A.M.M. en France) est à conserver pour la médecine humaine.
La durée de traitement à l’allopurinol dépend de la gravité de la maladie, la réponse clinique et parasitologique au traitement. Si pour certains chiens le traitement ne pourra jamais être arrêté, pour d’autres il pourra l’être lors de résolution clinique et biologique et une diminution marquée du taux d’anticorps.
Références
- Solano-Gallego, L., et al., LeishVet guidelines for the practical management of canine leishmaniosis. Parasit Vectors, 2011. 4 :p.86.
- Solano-Gallego, L., et al., Directions for the diagnosis, clinical staging, treatment and prevention of canine leishmaniosis. Vet Paraistol, 2009. 165(1-2) :p.1-18.
- Scott DW, Miller R, Griffin CE. Dermatologic therapy. In: Muller and Kirk’s Small Animal Dermatology. 6th ed. Philadelphia: WB Saunders 2001:534–538.
- Rougier, S., et al., Efficacy of different treatment regimens of marbofloxacin in canine visceral leishmaniosis : a pilot study. Vet Parasitol, 2008. 153(3-4) :p. 244-54.